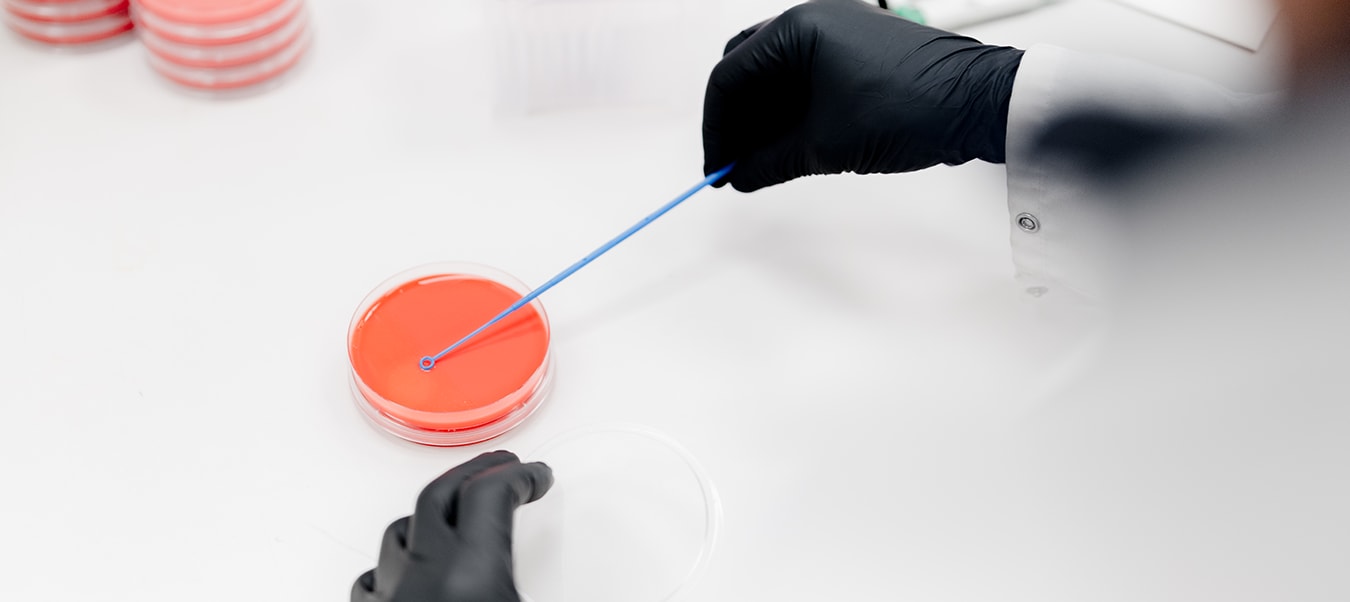

Analist Microbiologie
- Op locatie
- Woerden, Utrecht, Nederland
- € 2.549 - € 2.650 per maand
- Normec Foodcare
Ons microbiologisch lab in Woerden zoekt een Analist Microbiologie. Versterk ons team en help mee aan voedselveiligheid.
Functieomschrijving
Ben jij gepassioneerd door microbiologie en wil je bijdragen aan voedselveiligheid? Dan hebben wij de perfecte uitdaging voor jou! Voor ons ISO 17025-geaccrediteerde laboratorium in Woerden zijn wij op zoek naar een enthousiaste Analist Microbiologie.
Stap in de rol
Als Microbiologisch Analist voer je diverse analyses uit om de kwaliteit en veiligheid van voedingsmiddelen te waarborgen. Je werkt in een modern laboratorium met geavanceerde technieken en levert een directe bijdrage aan voedselveiligheid.
Wat ga je doen?
Uitvoeren van microbiologische analyses, waaronder:
Kiemgetalbepalingen
Detectie van pathogenen (Salmonella, Listeria, E. coli, Staphylococcus aureus)
Gist- en schimmelanalyses
Toepassen van moderne moleculaire technieken zoals PCR
Verwerken van analyseresultaten in het LIMS-systeem
Signaleren en rapporteren van afwijkingen volgens vastgestelde procedures
Ons aanbod
Je komt terecht in een gezellig en betrokken team binnen een groeiende internationale organisatie.
Daarnaast bieden wij:
Een jaarcontract met uitzicht op een vast dienstverband
Een salaris tussen €2.549 en €2.650 bruto per maand op basis van een fulltime dienstverband (afhankelijk van ervaring)
Een werkweek van 24 tot 40 uur in dagdienst
25 vakantiedagen en 8% vakantietoeslag
De mogelijkheid om extra vakantiedagen te kopen
Een goede pensioenregeling
Een continu ontwikkelprogramma waarin je jouw talenten verder kunt ontwikkelen
Toegang tot onze Online Academy met meer dan 800 gratis opleidingen
Reiskostenvergoeding en deelname aan het fietsplan
Collectieve zorgverzekering bij VGZ
Een actieve personeelsvereniging die het hele jaar door leuke activiteiten organiseert
Jouw profiel
Je bent een betrokken analist die graag samenwerkt en zorgvuldig te werk gaat. Daarnaast beschik je over:
Een afgeronde MLO- of HLO-opleiding (richting microbiologie, biologie of life sciences)
Ervaring met microbiologische technieken, opgedaan tijdens stage of werkervaring
Een flexibele en proactieve werkhouding. Je steekt graag de handen uit de mouwen
Stressbestendigheid, ook in drukke periodes
Een klantgerichte, collegiale en positieve instelling
Een sterk verantwoordelijkheidsgevoel
Over Normec
Normec, opgericht in 2016, is een ambitieuze, onafhankelijke en snelgroeiende organisatie met een Buy-&-Build-strategie gericht op testen, inspectie, certificering en compliance (TICC). Door deze specialisatie kunnen organisaties veilig, efficiënt en kosteneffectief innoveren. Dankzij aanzienlijke groei is Normec uitgegroeid tot een van Europa’s toonaangevende specialisten op het gebied van kwaliteit en veiligheid, met meer dan 5.500 medewerkers op 50 locaties. Tot nu toe zijn er meer dan 75 overnames voltooid in 9 landen en werkt de organisatie binnen 4 divisies.
Normec zet in op zowel organische groei als strategische overnames en bouwt partnerschappen die verder gaan dan de standaard aanpak. Elk project draagt bij aan een gedeelde, duurzame toekomst. Medewerkers krijgen de kans om bij te dragen aan deze missie en zich te ontwikkelen binnen een dynamische en snelgroeiende omgeving. Zo creëren we impactvolle oplossingen voor klanten en een duurzame toekomst.
Het microbiologisch laboratorium van Normec Foodcare te Woerden is een ISO 17025-erkend laboratorium en voert microbiologische analyses uit voor klanten uit alle branches binnen de levensmiddelenindustrie. Klantgerichtheid staat bij ons hoog in het vaandel. Dit blijkt uit de persoonlijke, op maat gesneden aanpak waarbij betrouwbare onderzoeksresultaten worden geleverd.
Interesse? Laten we kennismaken!
Ben je geïnteresseerd in deze vacature? Dan kijken we uit naar jouw sollicitatie! We behandelen jouw gegevens vertrouwelijk en zorgen ervoor dat je binnen vijf werkdagen een reactie van ons ontvangt. Voor vragen over deze vacature kun je contact opnemen met Johanna Pierhagen, senior recruiter bij Normec Foodcare, via 06 14889042. Zij helpt je graag verder!
De procedure:
Eerste telefonische screening en verdere bespreking van de vacature
Persoonlijk gesprek bij Normec
Referentiecheck (na jouw goedkeuring)
Tweede gesprek/bespreken arbeidsvoorwaarden bij Normec
Gefeliciteerd, je hebt je nieuwe uitdaging gevonden
Op zoek naar een nieuwe uitdaging binnen de voedingsmiddelenindustrie, maar is deze functie niet helemaal wat je zoekt? Volg Careers at Normec op LinkedIn en blijf op de hoogte van al onze vacatures.
Ongevraagde acquisitie door bureaus wordt niet op prijs gesteld en zal niet worden beantwoord.
Vereisten
of
Helemaal klaar!
Je sollicitatie is succesvol ingediend!
